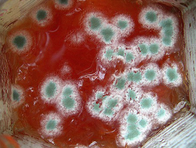
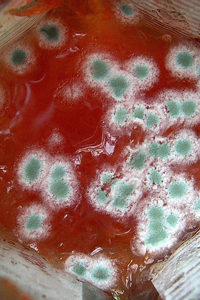

-
-
Je nachdem durch welche Faktoren der Verderb ausgelöst wird, spricht man von physikalisch-chemischem oder mikrobiologischem Verderb. Die Ursachen für den Verderb eines Lebensmittels können sehr vielfältig sein, häufig führen Fehler im Temperaturmanagement, zu lange Lagerung oder zu hohe Feuchtigkeit zu den beschriebenen sinnfälligen Veränderungen.
Aufgabe 1:
Heute präsentieren Sie grundlegende Fakten zum Themenbereich "Lebensmittelqualität und Verderb". Erstellen Sie dafür in Teams 10 Folien zu diesem Thema und verfassen Sie einen Begleittext zu den einzelnen Folien. Im Anschluss präsentieren Sie Ihren Mitschülern und Mitschülerinnen im Rahmen eines Rollenspiels die von Ihnen entwickelten Folien. Ihre MitschülerInnen haben nach Ihrer Präsentation 20 Minuten Zeit, Fragen zu weiteren Details zu stellen.
Folgende Inhalte sollen auf den 10 Folien, im Begleittext und im Abschlusstest berücksichtigt werden:
- Fachliche Hintergründe zu Ursachen und Erscheinungsbildern von Verderb
- Empfehlungen zur Verhinderung des Verderbs
- Umgang mit verdorbenen Lebensmitteln
Aufgabe 2:
Was ist passiert? Wie hätte man den Verderb verhindern können? Ist ein Schaden für die menschliche Gesundheit zu befürchten? Beantworten Sie diese Frage für folgende Lebensmittel:
- Verklumptes Salz
- Haselnusscremeschnitten liegen geöffnet über Nacht in der Küche, in der am Nachmittag Marmelade hergestellt wurde. Man hat vergessen den Raum zu lüften.
- Geöffnetes Öl schmeckt ranzig.
- Extrawurst weist eine Schleimschicht auf.